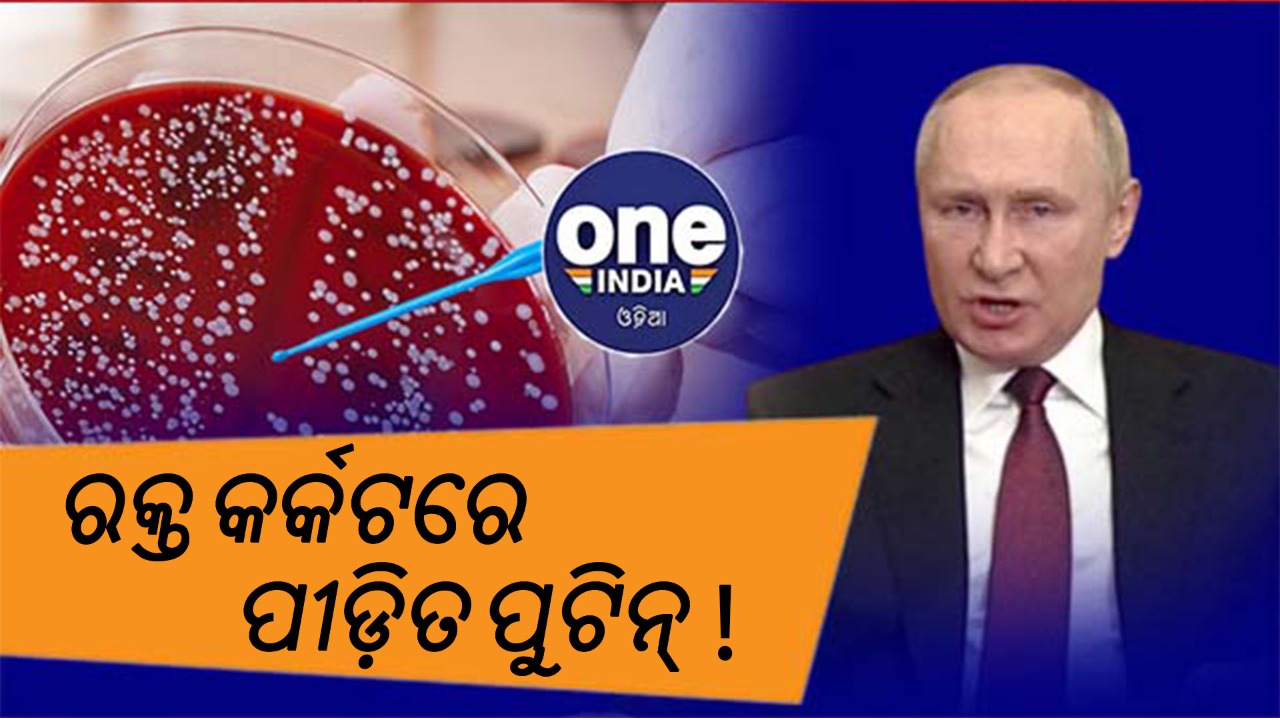

ଗୁରୁତର ଅସୁସ୍ଥ ଅଛନ୍ତି ରୁଷ୍ ରାଷ୍ଚ୍ରପତି : ପୂର୍ବତନ ଗୁପ୍ତଚର, ରକ୍ତ କର୍କଟରେ ଆକ୍ରାନ୍ତ : ପ୍ରଭାବଶାଳୀ ବ୍ୟବସାୟୀ
ଟେନର ଜଣେ ପୂର୍ବତନ ଗୁପ୍ତଚର କହିଛନ୍ତି "ଏହି ଅସୁସ୍ଥତା କ'ଣ ତାହା ସ୍ପଷ୍ଟ ନୁହେଁ - ଏହା ଆରୋଗ୍ୟ ହେଉ କିମ୍ବା ଟର୍ମିନାଲ୍ ହେଉ କିମ୍ବା ଯାହା ବି ହେଉ । କିନ୍ତୁ ଏନେଇ ନିଶ୍ଚିତ ହୋଇ ନଥିଲେ ମଧ୍ୟ ମୁଁ ଭାବୁଛି ଏହା ମଧ୍ୟରେ କିଛି ହୋଇଛି ।"
ନୂଆଦିଲ୍ଲୀ : ରୁଷର ରାଷ୍ଟ୍ରପତି ଭ୍ଲାଦିମିର ପୁଟିନ ଗୁରୁତର ଅସୁସ୍ଥ ଏ ଏହା ୟୁକ୍ରେନରେ ଘଟୁଥିବା ଘଟଣା ମଧ୍ୟରେ ଏହା ଆଲୋଚନାର ବିଷୟ ପାଲଟିଛି । ବ୍ରିଟେନର ଜଣେ ପୂର୍ବତନ ଗୁପ୍ତଚର କହିଛନ୍ତି "ଏହି ଅସୁସ୍ଥତା କ'ଣ ତାହା ସ୍ପଷ୍ଟ ନୁହେଁ - ଏହା ଆରୋଗ୍ୟ ହେଉ କିମ୍ବା ଟର୍ମିନାଲ୍ ହେଉ କିମ୍ବା ଯାହା ବି ହେଉ । କିନ୍ତୁ ଏନେଇ ନିଶ୍ଚିତ ହୋଇ ନଥିଲେ ମଧ୍ୟ ମୁଁ ଭାବୁଛି ଏହା ମଧ୍ୟରେ କିଛି ହୋଇଛି ।"
ଡୋନାଲ୍ଡ ଟ୍ରମ୍ପଙ୍କ ଉପରେ ଏକ ଡୋସିଅର୍ ଲେଖିଥିବା ଏବଂ 2016 ଆମେରିକୀୟ ନିର୍ବାଚନ ପ୍ରଚାରରେ ରୁଷର ହସ୍ତକ୍ଷେପ ରହିଥିଲା ବୋଲି ଖ୍ରୀଷ୍ଟୋଫର୍ ଷ୍ଟିଲ୍ ସ୍କାଏ ନ୍ୟୁଜ୍କୁ କହିଛନ୍ତି । ନିଶ୍ଚିତ ଭାବରେ ରୁଷ ଏବଂ ଅନ୍ୟାନ୍ୟ ଉତ୍ସରୁ ଆମେ ଯାହା ଶୁଣୁଛୁ, ପୁଟିନ ଗୁରୁତର ଅସୁସ୍ଥ ବୋଲି ସେ କହିଛନ୍ତି ।
ଏହି ସମୟରେ, ରୁଷର ନେତାଙ୍କ ସହ ଘନିଷ୍ଠ ସମ୍ପର୍କ ଥିବା ଜଣେ ପ୍ରଭାବଶାଳୀ ବ୍ୟବସାୟୀ କହିଛନ୍ତି ପୁଟିନ ରକ୍ତ କର୍କଟ ରୋଗରେ ପୀଡିତ ଅଛନ୍ତି । ସେ ଆହୁରି ମଧ୍ୟ କହିଛନ୍ତି ଯେ, ୟୁକ୍ରେନ୍ ଆକ୍ରମଣ କରିବା ପାଇଁ ଆଦେଶ ଦେବାର କିଛି ଦିନ ପୂର୍ବରୁ ରକ୍ତ କର୍କଟ ରୋଗ ଚିକିତ୍ସା ନିମନ୍ତେ ପୁଟିନ୍ଙ୍କ ପିଠିରେ ଅସ୍ତ୍ରୋପଚାର କରାଯାଇଥିଲା ।
ଗତ ସପ୍ତାହରେ ବିଜୟ ଦିବସ ସମାରୋହ ସମେତ ସାଧାରଣ କାର୍ଯ୍ୟକ୍ରମରେ ପୁଟିନ୍ ଦୁର୍ବଳ ଦେଖାଯାଉଥିବାରୁ ୟୁକ୍ରେନ ଯୁଦ୍ଧ ପରଠାରୁ ରୁଷର ରାଷ୍ଟ୍ରପତିଙ୍କ ସ୍ୱାସ୍ଥ୍ୟକୁ ନେଇ କଳ୍ପନାଜଳ୍ପନା ତୀବ୍ର ହୋଇଥିଲା ।












Click it and Unblock the Notifications